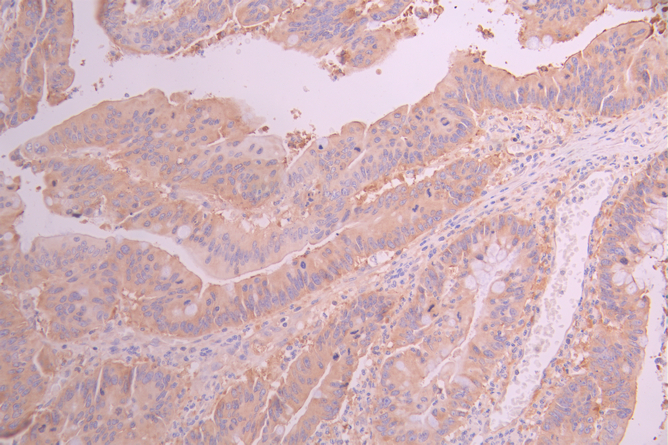

ABCE1 Recombinant Monoclonal Antibody
-
中文名稱:ABCE1 Recombinant Monoclonal Antibody
-
貨號:CSB-RA559722A0HU
-
規格:¥1320
-
圖片:
-
Western Blot
Positive WB detected in: PC-3 whole cell lysate(30μg),Jurkat whole cell lysate(30μg), Raji whole cell lysate(30μg), K562 whole cell lysate(30μg),MCF-7 whole cell lysate(30μg),A431 whole cell lysate(30μg),NIH/3T3 whole cell lysate(30μg)
All lanes: ABCE1 antibody at 1:1000
Secondary
Goat polyclonal to rabbit IgG at 1/40000 dilution
Predicted band size: 67 kDa
Observed band size: 67 kDa
Exposure time:2min -
IHC image of CSB-RA559722A0HU diluted at 1:100 and staining in paraffin-embedded human colorectal cancer performed on a Leica BondTM system. After dewaxing and hydration, antigen retrieval was mediated by high pressure in a citrate buffer (pH 6.0). Section was blocked with 10% normal goat serum 30min at RT. Then primary antibody (1% BSA) was incubated at 4°C overnight. The primary is detected by a Goat anti-rabbit polymer IgG labeled by HRP and visualized using 0.05% DAB.
-
IHC image of CSB-RA559722A0HU diluted at 1:100 and staining in paraffin-embedded human testis tissue performed on a Leica BondTM system. After dewaxing and hydration, antigen retrieval was mediated by high pressure in a citrate buffer (pH 6.0). Section was blocked with 10% normal goat serum 30min at RT. Then primary antibody (1% BSA) was incubated at 4°C overnight. The primary is detected by a Goat anti-rabbit polymer IgG labeled by HRP and visualized using 0.05% DAB.
-
Overlay Peak curve showing jurkat cells stained with CSB-RA559722A0HU (red line) at 1:100. The cells were fixed in 4% formaldehyde and permeated by 0.2% TritonX-100 for 10min. Then 10% normal goat serum to block non-specific protein-protein interactions followed by the antibody (1ug/1*106cells) for 45min at 4℃. The secondary antibody used was FITC-conjugated goat anti-rabbit IgG (H+L) at 1/200 dilution for 35min at 4℃.Control antibody (green line) was Rabbit IgG (1ug/1*106cells) used under the same conditions. Acquisition of >10,000 events was performed.
-
-
其他:
產品詳情
-
Uniprot No.:
-
基因名:ABCE1
-
別名:2' 5' oligoadenylate binding protein antibody; 2''-5''-oligoadenylate-binding protein antibody; 2'5' oligoadenylate binding protein antibody; ABC 38 antibody; ABC38 antibody; ABCE 1 antibody; ABCE1 antibody; ABCE1_HUMAN antibody; ATP binding cassette sub family E (OABP) member 1 antibody; ATP binding cassette sub family E member 1 antibody; ATP-binding cassette sub-family E member 1 antibody; HuHP 68 antibody; HuHP68 antibody; OABP antibody; Ribonuclease 4 inhibitor antibody; Ribonuclease L (2' 5' oligoisoadenylate synthetase dependent) inhibitor antibody; Ribonuclease L (2'5' oligoisoadenylate synthetase dependent) inhibitor antibody; Ribonuclease L inhibitor antibody; RLI antibody; RNase L inhibitor antibody; RNASEL1 antibody; RNASELI antibody; RNS 4I antibody; RNS4I antibody
-
反應種屬:Human, Mouse
-
免疫原:A synthesized peptide derived from human ABCE1
-
免疫原種屬:Homo sapiens (Human)
-
標記方式:Non-conjugated
-
克隆類型:Monoclonal
-
抗體亞型:Rabbit IgG
-
純化方式:Affinity-chromatography
-
克隆號:3D3
-
濃度:It differs from different batches. Please contact us to confirm it.
-
保存緩沖液:Rabbit IgG in 10mM phosphate buffered saline , pH 7.4, 150mM sodium chloride, 0.05% BSA, 0.02% sodium azide and 50% glycerol.
-
產品提供形式:Liquid
-
應用范圍:ELISA, WB, IHC, FC
-
推薦稀釋比:
Application Recommended Dilution WB 1:500-1:2000 IHC 1:50-1:200 FC 1:50-1:200 -
Protocols:
-
儲存條件:Upon receipt, store at -20°C or -80°C. Avoid repeated freeze.
-
貨期:Basically, we can dispatch the products out in 1-3 working days after receiving your orders. Delivery time maybe differs from different purchasing way or location, please kindly consult your local distributors for specific delivery time.
-
用途:For Research Use Only. Not for use in diagnostic or therapeutic procedures.
相關產品
靶點詳情
-
功能:Cotranslational quality control factor involved in the No-Go Decay (NGD) pathway. Together with PELO and HBS1L, is required for 48S complex formation from 80S ribosomes and dissociation of vacant 80S ribosomes. Together with PELO and HBS1L, recognizes stalled ribosomes and promotes dissociation of elongation complexes assembled on non-stop mRNAs; this triggers endonucleolytic cleavage of the mRNA, a mechanism to release non-functional ribosomes and to degrade damaged mRNAs as part of the No-Go Decay (NGD) pathway. Plays a role in the regulation of mRNA turnover. Plays a role in quality control of translation of mitochondrial outer membrane-localized mRNA. As part of the PINK1-regulated signaling, ubiquitinated by CNOT4 upon mitochondria damage; this modification generates polyubiquitin signals that recruit autophagy receptors to the mitochondrial outer membrane and initiate mitophagy. RNASEL-specific protein inhibitor which antagonizes the binding of 2-5A (5'-phosphorylated 2',5'-linked oligoadenylates) to RNASEL. Negative regulator of the anti-viral effect of the interferon-regulated 2-5A/RNASEL pathway.; (Microbial infection) May act as a chaperone for post-translational events during HIV-1 capsid assembly.; (Microbial infection) Plays a role in the down-regulation of the 2-5A/RNASEL pathway during encephalomyocarditis virus (EMCV) and HIV-1 infections.
-
基因功能參考文獻:
- Induction of ribosome rescue factors PELO and HBS1L is required to support protein synthesis when ABCE1 levels fall in platelets, including for hemoglobin production during blood cell development. PMID: 27681415
- ABCE1 is involved in histone biosynthesis and DNA replication and therefore is essential for normal S phase progression. PMID: 26985706
- The present study reported on the effects of ABCE1 overexpression on lung adenocarcinoma cells in vitro, demonstrating its enhancing effect on cell proliferation and invasiveness with simultaneous downregulation of p27 protein expression. PMID: 27314749
- ABCE1 plays an essential role in the progression and metastasis of lung cancers and may represent a valuable therapeutic target for the management of lung tumor PMID: 26733164
- miR-299-3p promotes the sensibility of lung cancer to doxorubicin through suppression of ABCE1, at least partly. Therefore, the disordered decreased of miR-299-3p and resulting ABCE1 up-expression may contribute to chemoresistance of lung cancer PMID: 26617714
- Expression of the ABCE1-silencing gene, transfected by electrotransfer, could inhibit the proliferation, invasion, and migration of thyroid cancer cells. PMID: 26600528
- Downregulation of ABCE1 via siRNA affects the sensitivity of lung cancer cells against chemotherapeutic agents. PMID: 25744244
- ABCE1 is closely associated with cell proliferation, invasion and migration in esophageal cancer and silencing the ABCE1 gene by electroporation can significantly reduce the proliferation, invasion and migration capacity PMID: 25815591
- ABCE1 is able to suppress RNA silencing in Nicotiana benthamiana plants, in mammalian HEK293 cells and in the worm Caenorhabditis elegans. PMID: 25659154
- ABCE1 is closely connected with the pathogenesis and development of oral cancer, which acts through the cellular pathways of 2-5A/RNase L. PMID: 25337191
- ABCE1 is closely connected with the pathogenesis and development of esophageal carcinoma, which act through the cellular pathways of 2-5A/RNase L. PMID: 24551278
- Studies indicate a strong sequence conservation of ABC-type ATPase ABCE1 in eukaryotes and archaea. PMID: 23266104
- ABCE1 protein regulates a broad range of biological functions including viral infection, tumor cell proliferation, and antiapoptosis. (Review) PMID: 23008114
- Pulse chase experiments and immunoelectron microscopy shows that HIV-1 Gag associates transiently with ABCE1 during HIV-1 capsid assembly, including at the plasma membrane where assembly is completed. PMID: 17233757
- HIV-1, HIV-2, SIV mac239, and SIVagm Gag proteins form ABCE1-containing assembly intermediates during immature capsid formation, indicating that Gag proteins of these diverse retroviruses bind to ABCE1 despite the limited homology between these Gags. PMID: 14747530
- For binding of WT HIV-1 Gag to the cellular ATPase ABCE1, which facilitates HIV-1 capsid assembly, the basic residues in the nucleocapsid domain of Gag are required but the cysteine and histidine residues in the nucleocapsid domain are dispensable. PMID: 16275648
- During assembly of an immature HIV-1 capsid, HIV-1 Gag progresses through a pathway of sequential assembly intermediates that contain ABCE1, a cellular ATPase that was found to facilitate capsid formation. PMID: 11780123
- To form HIV-1 capsid assembly intermediates, HIV-1 Gag co-opts a complex found in infected and uninfected cells that contains the cellular ATPase ABCE1 and the RNA helicase DDX6, both of which facilitate HIV-1 capsid assembly. PMID: 22851315
- Report high expression level of ABCE1 mRNA and protein in human lung adenocarcinoma tissues and metastatic lymph nodes, which was also correlated with clinical stages. PMID: 22267055
- Pelota/Hbs1 induced dissociation of elongation complexes from ribosomes and release of peptidyl-tRNA, but only in the presence of ABCE1. PMID: 21448132
- Results suggest that ABCE1 plays an important role in the pathogenesis of human small cell lung cancer cell. PMID: 20372810
- NTP hydrolysis by ABCE1 is stimulated by posttermination complexes and is required for its ribosomal recycling activity. PMID: 20122402
- were able to confirm the excess of rare genetic variation among HIV-1-positive African-American individuals (n=53; Tajima's D=-2.34). These results highlight the potential importance of ABCE1's role in infectious diseases such as HIV-1. PMID: 19657357
- HIV-2 Gag associates with human HP68 in a cell-free system and that Gag proteins of HIV-2, simian immunodeficiency virus SIVmac239, and SIVagm associate with endogenous HP68 in primate cells, as is seen for HIV-1. PMID: 14747530
- overexpression in a permissive cell line had no significant effect on varicella zoster virus replication PMID: 15107989
- ABCE1 and its peptides could be target molecules in specific immunotherapy for HLA-A2(+) colon cancer patients. PMID: 15809757
- The primary role of ABCE-1 in the effect of TULA appears to be the recruitment of TULA to the sites of HIV-1 assembly where TULA interferes with the late steps of the HIV-1 life cycle. PMID: 18006034
- host protein essential for assembly of immature HIV-1 capsids PMID: 11780123
顯示更多
收起更多
-
亞細胞定位:Cytoplasm. Mitochondrion. Note=Localized to clusters of virus formation at the plasma membrane.
-
蛋白家族:ABC transporter superfamily, ABCE family
-
數據庫鏈接:
Most popular with customers
-
-
Phospho-YAP1 (S127) Recombinant Monoclonal Antibody
Applications: ELISA, WB, IHC
Species Reactivity: Human
-
-
-
-
-
-